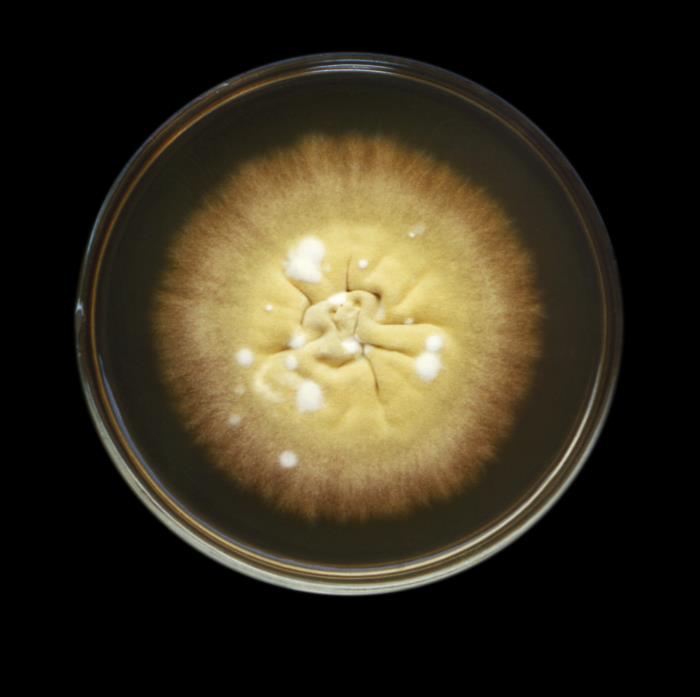
Colonia de E. floccosum. CDC Public Health Image Library (PHIL)

Epidermophyton floccosum es un hongo filamentoso, perteneciente al filo Ascomycota, antropofílico.
Microscópicamente presenta abundantes macroconidios en racimos, con pared gruesa y lisa y con extremos romos, lo que le da un aspecto de maza, divididos con 2-4 septos. Sin microconidios. En cultivos viejos aparece con hifas en raqueta y clamidosporas.
Macroscópicamente las colonias son aterciopeladas y amarillentas en una semana, después de aspecto pulverulento y plano, umbilicadas con surcos, de color verde amarillento a verde oliva, reverso amarillento con centro naranja o amarillo parduzco, con el tiempo se vuelven flocosas y estériles.
Viabilidad, propagación y transmisión
Reservorio
Humano, suelo y fómites.
Hospedadores
Humanos.
Dosis Infectiva Mínima (DIM)
Se desconoce en la actualidad.
Supervivencia ambiental
Puede vivir en distintas superficies, en el suelo, en el agua dulce y salada y meses en escamas de la piel a temperatura ambiente.
Formas de resistencia
Esporas.
Mecanismo de propagación y transmisión
La transmisión se produce principalmente por el contacto directo o indirecto. Contacto con la piel o con las lesiones de un individuo afectado, así como con fómites, utensilios de uso personal contaminados (toallas, guantes, duchas, vestuarios).
Pueden darse brotes epidémicos en instituciones cerradas (1).
Vías de entrada
Dérmica.
Distribución geográfica
Mundial.
Efectos sobre la salud
Grupo de riesgo
2 A
(Ver Anexo II RD 664/1997 )Infección
Dermatofitosis o tiñas: micosis superficiales que pueden afectar a distintas partes del cuerpo (pelo, piel, uñas), recibiendo distintos nombres en función de la zona afectada: tinea cruris, tinea pedis o pie de atleta y tinea unguium u onicomicosis (uña). Las manifestaciones clínicas son lesiones eccematosas, a veces, formación de vesículas y pústulas, intertrigo, decoloración de las uñas.
Efectos alérgicos (Ver Anexo II RD 664/1997 ) / (Ver Allergen )
Sí
Efectos tóxicos (Ver Anexo II RD 664/1997 )
No se han descrito
Efectos cancerígenos (Ver International Agency for Research On Cancer - IARC )
No se han descrito
Efectos en la maternidad
No se han descrito
Enfermedad
| CIE-10 | Nombre | Enfermedad de Declaración Obligatoria |
|---|---|---|
| B35 | Dermatofitosis | No |
Actividades laborales con riesgo
Clasificación Nacional de Actividades Económicas (CNAE)
| CNAE 2009 | Descripción |
|---|---|
| A0112 | Cultivo de arroz |
| E3600 | Captación, depuración y distribución de agua |
| E3700 | Recogida y tratamiento de aguas residuales |
| F4322 | Fontanería, instalación de sistemas de calefacción y aire acondicionado |
| N7210 | Investigación y desarrollo experimental en ciencias naturales y técnicas |
| O8123 | Otras actividades de limpieza |
| O8130 | Actividades de jardinería |
| P8424 | Orden público y seguridad |
| P8425 | Servicios de extinción de incendios |
| Q8510 | Educación preprimaria |
| Q8520 | Educación primaria |
| R8610 | Actividades hospitalarias |
| R8621 | Actividades de medicina general y de medicina familiar y comunitaria |
| R8622 | Actividades de otras especialidades médicas |
| R8699 | Otras actividades sanitarias n.c.o.p. |
| R8710 | Asistencia en establecimientos residenciales con cuidados sanitarios |
| R8720 | Asistencia en establecimientos residenciales para personas que padecen una enfermedad mental o una drogodependencia o que han recibido un diagnóstico al respecto |
| R8731 | Asistencia en establecimientos residenciales para personas mayores |
| R8732 | Asistencia en establecimientos residenciales para personas con discapacidad física |
| R8811 | Actividades de servicios sociales sin alojamiento para personas mayores |
| R8812 | Actividades de servicios sociales sin alojamiento para personas con discapacidad |
| R8891 | Actividades de cuidado diurno de niños |
| S9141 | Actividades de los jardines botánicos y los parques zoológicos |
| S9311 | Gestión de instalaciones deportivas |
| S9329 | Actividades recreativas y de entretenimiento n.c.o.p. |
Clasificación Nacional de Ocupaciones (CNO)
| CNO 2011 | Descripción |
|---|---|
| 2112 | Otros médicos especialistas |
| 2121 | Enfermeros no especializados |
| 2122 | Enfermeros especializados (excepto matronos) |
| 2421 | Biólogos, botánicos, zoólogos y afines |
| 3132 | Técnicos en instalaciones de tratamiento de residuos, de aguas y otros operadores en plantas similares |
| 3141 | Técnicos en ciencias biológicas (excepto en áreas sanitarias) |
| 3313 | Técnicos en anatomía patológica y citología |
| 3314 | Técnicos en laboratorio de diagnóstico clínico |
| 5611 | Auxiliares de enfermería hospitalaria |
| 5612 | Auxiliares de enfermería de atención primaria |
| 5622 | Técnicos de emergencias sanitarias |
| 5629 | Trabajadores de los cuidados a las personas en servicios de salud no clasificados bajo otros epígrafes |
| 5710 | Trabajadores de los cuidados personales a domicilio |
| 5721 | Cuidadores de niños en guarderías y centros educativos |
| 5722 | Cuidadores de niños en domicilios |
| 5893 | Cuidadores de animales y adiestradores |
| 5910 | Guardias civiles |
| 5921 | Policías nacionales |
| 5922 | Policías autonómicos |
| 5923 | Policías locales |
| 5991 | Vigilantes de prisiones |
| 5992 | Bañistas-socorristas |
| 6110 | Trabajadores cualificados en actividades agrícolas (excepto en huertas, invernaderos, viveros y jardines) |
| 6120 | Trabajadores cualificados en huertas, invernaderos, viveros y jardines |
| 7250 | Mecánicos-instaladores de refrigeración y climatización |
| 9229 | Otro personal de limpieza |
| 9442 | Clasificadores de desechos, operarios de punto limpio y recogedores de chatarra |
| 9443 | Barrenderos y afines |
| 9511 | Peones agrícolas (excepto en huertas, invernaderos, viveros y jardines) |
| 9512 | Peones agrícolas en huertas, invernaderos, viveros y jardines |
Prevención y control
Desinfectantes
Cloruro de benzalconio, compuestos fenólicos, formaldehído, glutaraldehído, yodóforos e hipoclorito sódico al 1% (7).
Inactivación física
Se inactiva con radiación ultravioleta C, microondas y con calor húmedo a 121ºC durante al menos 20 minutos, y con calor seco a 170ºC durante al menos 2 horas.
Antimicrobianos
Griseofulvina, ketoconazol, itraconazol, fluconazol, terbinafina, voriconazol, clotrimazol, etc. (6).
Vacunación
No disponible
Medidas preventivas generales
Evitar el exceso de humedad y de temperatura en los locales de trabajo.
Orden y limpieza en el lugar de trabajo (la limpieza preferiblemente con métodos de aspirado para eliminar escamas y pelos). Desinfección de instalaciones, equipos y materiales.
Higiene personal, mantener la piel limpia y seca, especialmente en las zonas de los pliegues, lavado de manos después de tocar materiales o elementos potencialmente contaminados.
Utilizar ropa de trabajo que permita la transpiración y evite la sudoración excesiva. Cambiarse la ropa o el calzado mojado o húmedo. No compartir objetos personales, toallas, calzado, equipos de protección individual (guantes).
Precauciones en centros sanitarios
EPI
Protección de las manos: guantes impermeables para manipular especímenes, pacientes o materiales que puedan estar contaminados.
Protección ocular o facial: gafa de protección de montura universal en caso de riesgo de contacto accidental mano/guante contaminado-ojo, o pantalla de protección facial (símbolo de marcado en montura: 3) en caso de riesgo de exposición a salpicaduras.
Seguridad en laboratorio
Nivel de contención 2
Los principales riesgos son la exposición de la piel al manipular cultivos del agente, muestras o materiales contaminados.
Las muestras o especímenes más peligrosos son tejidos queratinizados (piel, pelo, uñas) de pacientes afectados, muestras de suelo contaminadas o útiles contaminados.
Se requieren las prácticas y la contención de un nivel 2 de bioseguridad, evitar el empleo de material cortante o punzante, utilizar cabina de seguridad biológica en aquellas operaciones que impliquen la generación de bioaerosoles, proyecciones o salpicaduras y utilizar guantes impermeables en el caso de contacto con muestras contaminadas.
Bibliografía
- Pontón, J., Moragues, M. D., Gené, J., Guarro, J., & Quindós, G. (2002). Hongos y actinomicetos alergénicos. Revista Iberoamericana de Micología.
- Centers for Disease Control and Prevention (CDC). (2019). Guideline for isolation precautions: preventing transmission of infectious agents in healthcare settings. CDC: Infection control.
- Institut National de Recherche et de Sécurité (INRS). (2023). Epidermophyton floccosum. BAse d'OBservation des Agents Biologiques (BAOBAB).
- Instituto Nacional de Seguridad y Salud en el Trabajo (INSST). Notas Técnicas de Prevención (NTP): 539, 689, 700, 802, 822, 858 y 938.
- Servicio Riojano de Salud. (2008). Precauciones de aislamiento en centros sanitarios.
- Public Health Agency of Canada. (2010). Epidermophyton floccosum, Microsporum spp., Trichophyton spp. Pathogen Safety Data Sheets.
- The Center for Food Security and Public Health (CFSPH). (2013). Dermatophytosis. CFSPH: Disease information.
- UK Health Security Agency. Epidermophyton floccosum. National Collection of Pathogenic Fungi.